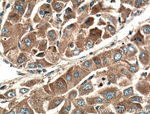
MCP1 Antibody in Immunohistochemistry (Paraffin) (IHC (P))

Search
Proteintech
MCP1 Polyclonal Antibody
{{$productOrderCtrl.translations['antibody.pdp.commerceCard.promotion.promotions']}}
{{$productOrderCtrl.translations['antibody.pdp.commerceCard.promotion.viewpromo']}}
{{$productOrderCtrl.translations['antibody.pdp.commerceCard.promotion.promocode']}}: {{promo.promoCode}} {{promo.promoTitle}} {{promo.promoDescription}}. {{$productOrderCtrl.translations['antibody.pdp.commerceCard.promotion.learnmore']}}
产品信息
25542-1-AP
已发表种属
宿主/亚型
分类
类型
抗原
偶联物
形式
浓度
规格
保存条件
运输条件
产品详细信息
Immunogen sequence: MKVSAALLC LLLIAATFIP QGLAQPDAIN APVTCCYNFT NRKISVQRLA SYRRITSSKC PKEAVIFKTI VAKEICADPK QKWVQDSMDH LDKQTQTPKT (1-99 aa encoded by BC009716 )
靶标信息
This gene is one of several cytokine genes clustered on the q-arm of chromosome 17. Cytokines are a family of secreted proteins involved in immunoregulatory and inflammatory processes. The protein encoded by this gene is structurally related to the CXC subfamily of cytokines. Members of this subfamily are characterized by two cysteines separated by a single amino acid. This cytokine displays chemotactic activity for monocytes and basophils but not for neutrophils or eosinophils. It has been implicated in the pathogenesis of diseases characterized by monocytic infiltrates, like psoriasis, rheumatoid arthritis and atherosclerosis. It binds to chemokine receptors CCR2 and CCR4.
仅用于科研。不用于诊断过程。未经明确授权不得转售。